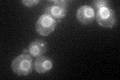
YIL090W
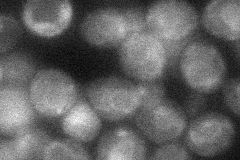
YIL090W

View description
Integral ER membrane protein with type-III transmembrane domains; mutations cause defects in cortical ER morphology in both the mother and daughter cells
Localization:
Intensity:
Fold change:
Significance:
-
C’ GFP library in SD
ER45.58 -
N' NOP1pr-GFP in SD

ER62.876 -
N' TEF2pr-mCherry in SD

ER86.7693 -
N' NATIVEpr-GFP in SD

below threshold20.5166 -
N' TEF2pr-VC and Cyto-VN in SD
ER34.5762 -
C’ GFP library in SD+DTT

ER34.780.76No -
C’ GFP library in SD+H2O2

ER37.090.81No -
C’ GFP library in Starvation Media

punctate, ERN/AN/AYes -
C’ GFP library on the background of Pup2-DaMP

ER -
C’ GFP library on the background of CCT mutant

ER39.22150.860332No
